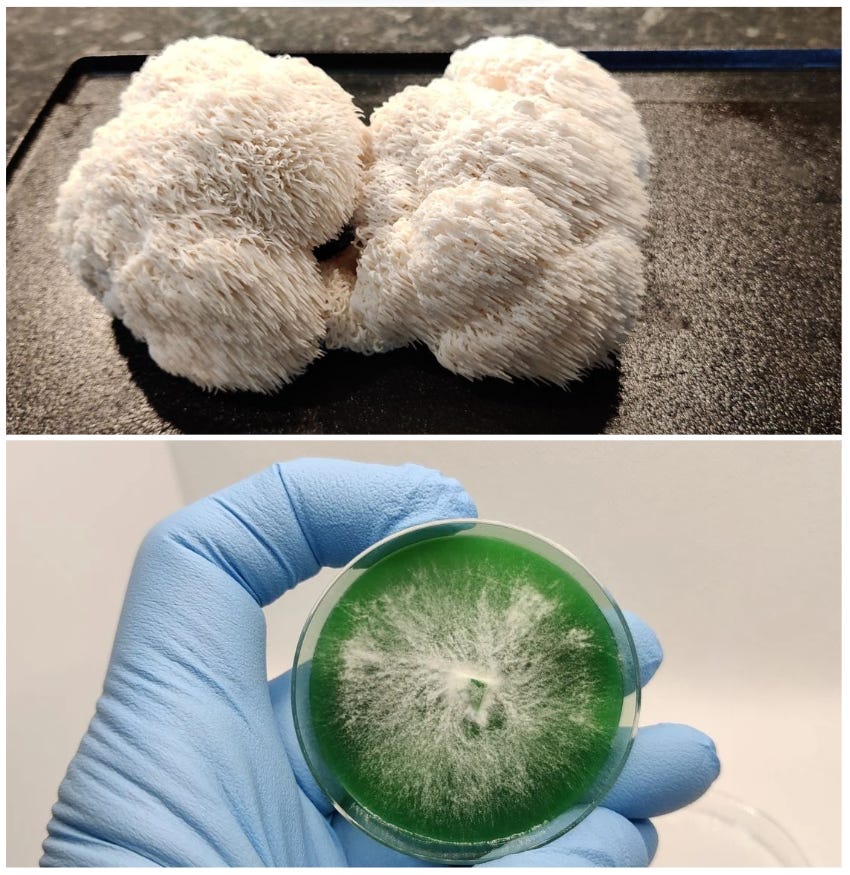
Galleribilde

Bildegalleri
(1/1)
Lion's Mane / Hericium Erinaceus / Piggsvinsopp / Pinnsvinsopp
Til salgs
Beskrivelse av varen
- Hericium Erinaceus Mycelium - Agarkultur (Petriskål) // kr. 249 per stk.
- Frakt, liten pakke // kr. 76: opptil 5 kg, innenfor 35 × 25 × 12 cm.
- Inntil 14 dager leveringstid. Platene produserer på bestilling.
- Det sikres at det er rene kulturer før de sendes i posten.
- Sender kun til Norske adresser.
- Kjøper betaler frakt, og beløpet i sin helhet forhåndsbetales per Vipps.
Ta kontakt dersom du har spørsmål om produktet. Men jeg håper du har forståelse for at jeg ikke driver med veiledning eller opplæring. Jeg anbefaler deg å lese deg godt opp før du går til anskaffelse av soppkulturer.
NB: Knappen for å vise hele beskrivelsen har kun en visuell effekt.
Brukerprofil

Du må være logget inn for å se brukerprofiler og sende meldinger.
Logg innAnnonsens metadata
Sist endret: 7.5.2026 kl. 12:28 ・ FINN-kode: 343093836
Gratis frakt på kjoler til dame til og med 14. juni
Ta en titt